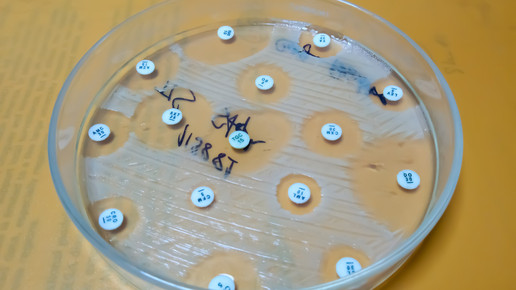

Neue antibakterielle Molekülgruppe entdeckt
Forscher:innen der Universität Bonn, des Karolinska Instituts und der Universität Umeå in Schweden haben eine neue Molekülgruppe mit antibakterieller Wirkung identifiziert. Sie könnte in Zukunft die Basis für dringend benötigte Antibiotika darstellen.
Zunehmende Antibiotikaresistenzen sind ein weltweites Problem. „Erschwerend kommt hinzu, dass in den letzten 50 Jahren nur wenige neue Typen von Antibiotika entwickelt worden sind. Es besteht daher ein großer Bedarf an neuen antibiotischen Wirkstoffen“, erklärt die Uni Bonn. Die altbekannten Antibiotika hindern die Bakterien daran, eine schützende Zellwand zu bilden. Dadurch lösen sich die Zellen auf. Es gibt jedoch Antibiotika, die anders angreifen: Penicillin beispielsweise stört bestimmte Enzyme beim Aufbau der Zellwand und auch neuere Wirkstoffe wie Daptomycin oder Teixobactin verfügen über andere Wirkmechanismen.
Lipid-II als Angriffspunkt
Sie binden an einen speziellen Baustein, das sogenannte „Lipid II“, welches von Bakterien zum Aufbau der Zellwand benötigt wird. „Lipid II-bindende Antibiotika sind in der Regel sehr große und komplexe Naturstoffe, die sich mit chemischen Methoden nicht leicht verbessern lassen.“ Zudem seien sie aufgrund ihrer Größe meist gegenüber Problemkeimen, die über eine weitere Hülle – die sogenannte äußere Membran verfügen – nicht wirksam.
Dem Forscherteam ist nun jedoch ein bedeutender Schritt gelungen: „Wir haben die ersten kleinen antibakteriellen Verbindungen identifiziert, die durch Bindung an dieses Lipidmolekül wirken, und in unserer Studie haben wir keine resistenten Bakterienmutanten gefunden, was sehr vielversprechend ist”, erklärt Birgitta Henriques Normark, Professorin in der Abteilung für Mikrobiologie, Tumor- und Zellbiologie am Karolinska Institut. Lipid II sei somit ein sehr attraktives Ziel für neue Antibiotika.
Bildung der Bakterien-Zellwand wird gehemmt
Im Zuge der Untersuchung fand das Team heraus, dass eine Gruppe von Molekülen namens „THCz“ die Bildung der Bakterien-Zellwand durch Bindung an Lipid II hemmt. „Die Moleküle könnten auch die Bildung einer schützenden Kapsel verhindern, die die Pneumokokken umgibt und die sie benötigen, um dem Immunsystem zu entgehen und Krankheiten zu verursachen“, erklären die Wissenschaftler:innen.
„Der Vorteil von kleinen Molekülen wie diesen ist, dass sie chemisch leichter zu modifizieren sind. Wir hoffen, dass wir THCz so verändern können, dass die antibakterielle Wirkung zunimmt und die negativen Auswirkungen auf menschliche Zellen abnehmen”, meint Fredrik Almqvist, Professor am Fachbereich Chemie der Universität Umeå.
Im Labor konnten bereits antibakterielle Wirkungen gegen viele antibiotikaresistente Bakterien herausgestellt werden, unter anderem:
- Methicillin-resistente Staphylokokken (MRSA)
- Vancomycin-resistente Enterokokken (VRE)
- Penicillin-resistente Pneumokokken (PNSP)
- Gonokokken
- Mykobakterien

APOTHEKE ADHOC Debatte